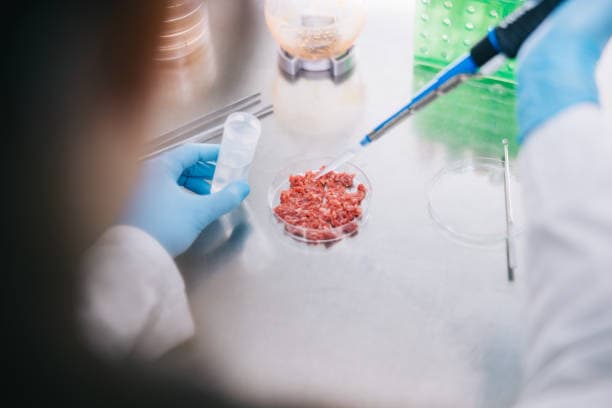
배양육의 가장 큰 문제점은? 생산, 비용, 그리고 규제

1. 배양육 생산의 기술적 한계: 대규모 생산의 도전
배양육 생산은 기존 육류 산업에 비해 기술적으로 복잡한 과정을 요구합니다. 동물의 세포를 채취하여 배양하는 초기 단계는 상대적으로 간단해 보이지만, 이를 대규모로 확장하여 안정적이고 일관된 품질의 제품을 생산하는 것은 매우 어려운 과제입니다. 특히, 세포 배양 과정에서 필요한 특정 환경(온도, 영양소, 산소 농도 등)을 유지하는 것은 민감한 기술이 요구됩니다.
또한, 현재 사용되는 배양액의 주요 성분 중 하나는 동물성 혈청으로, 이를 대체할 식물성 배양액 개발이 진행되고 있으나 완전한 대체 기술은 아직 상용화되지 않았습니다. 이러한 기술적 제약은 배양육의 대량 생산을 지연시키는 원인으로 작용하며, 생산량이 제한되면서 공급 부족과 높은 가격 문제가 지속되고 있습니다.
2. 비용 문제: 고가의 생산 과정과 소비자 접근성
배양육의 가장 큰 문제 중 하나는 높은 생산 비용입니다. 초기 연구 개발 단계에서는 1kg당 수십만 달러에 이르던 생산비용이 점차 낮아지고 있지만, 여전히 전통적인 육류와 비교하면 비싼 수준입니다. 세포 배양에 필요한 장비와 재료, 특히 배양액의 높은 가격이 전체 생산 비용의 상당 부분을 차지합니다.
소비자들에게 매력적으로 다가가기 위해서는 가격 경쟁력을 확보해야 하지만, 현재 상태로는 전통 육류의 시장 가격과 비교하여 큰 차이를 보이고 있습니다. 이는 생산 공정을 효율화하고 비용을 절감하기 위한 추가적인 기술 개발이 필요하다는 점을 시사합니다. 비용 문제를 해결하지 못하면, 배양육은 환경적·윤리적 이점에도 불구하고 주류 시장에서 자리 잡기 어려울 것입니다.
3. 규제의 복잡성: 안전성과 승인 과정의 난관
배양육이 상업적으로 성공하기 위해서는 각국의 규제 기관으로부터 안전성과 적합성을 인정받아야 합니다. 그러나 배양육은 기존 식품과 생산 방식이 근본적으로 다르기 때문에, 이를 규정할 명확한 법적 기준이 부족한 상황입니다. 규제 당국은 배양육의 생산 과정, 성분, 환경적 영향 등을 철저히 검토해야 하지만, 이러한 과정은 시간이 오래 걸리고 복잡한 절차를 요구합니다.
특히, 배양육의 안전성을 보장하기 위한 테스트와 평가 과정에서 기술적 문제와 소비자의 우려가 제기될 수 있습니다. 규제 기관이 배양육에 대한 명확한 지침을 제시하지 않는다면, 이는 기업들이 상업화에 도달하는 속도를 크게 늦출 수 있습니다. 미국, 유럽, 싱가포르 등 일부 국가에서 규제 승인 사례가 나오고 있지만, 전 세계적으로 일관된 규제 체계가 마련되기까지는 상당한 시간이 소요될 것입니다.
4. 배양육의 미래: 문제 해결을 위한 방향성
배양육이 직면한 문제들은 해결이 어려운 도전 과제지만, 이를 극복하기 위한 노력이 전 세계적으로 진행되고 있습니다. 기술적 한계를 극복하기 위해 과학자들은 효율적이고 저렴한 배양액 개발과 대규모 생산 시설 구축에 박차를 가하고 있습니다. 동시에, 정부와 민간 투자자들은 연구 개발에 필요한 자금을 지원하며, 배양육의 상용화를 촉진하려고 노력하고 있습니다.
규제 문제를 해결하기 위해서는 정부와 기업 간의 협력이 필수적입니다. 규제 기관은 배양육의 안전성을 보장하기 위한 명확하고 투명한 기준을 마련해야 하며, 소비자 신뢰를 구축하기 위한 정보 공개와 교육이 필요합니다. 비용 문제는 시간이 걸리겠지만, 기술 혁신과 생산 효율화가 이루어진다면 장기적으로 해결될 가능성이 높습니다. 결국, 배양육이 지속 가능한 미래를 위한 핵심적인 식품으로 자리 잡으려면, 기술적·경제적·규제적 과제를 해결하는 데 중점적으로 노력해야 할 것입니다.
'배양육' 카테고리의 다른 글
| 대중을 배양육을 받아들일 준비가 되었는가? (0) | 2025.01.18 |
|---|---|
| 할랄·코셔 배양육: 종교적 기준을 만족시킬 수 있을까? (0) | 2025.01.18 |
| 채식주의자도 배양육을 먹을까? 윤리적 딜레마 (0) | 2025.01.18 |
| 배양육 가격 언제 낮아질까? 대중화의 경제적 도전 (0) | 2025.01.18 |
| 배양육, 전통 요리에 도전하다: 음식 문화의 변화 (0) | 2025.01.18 |




댓글